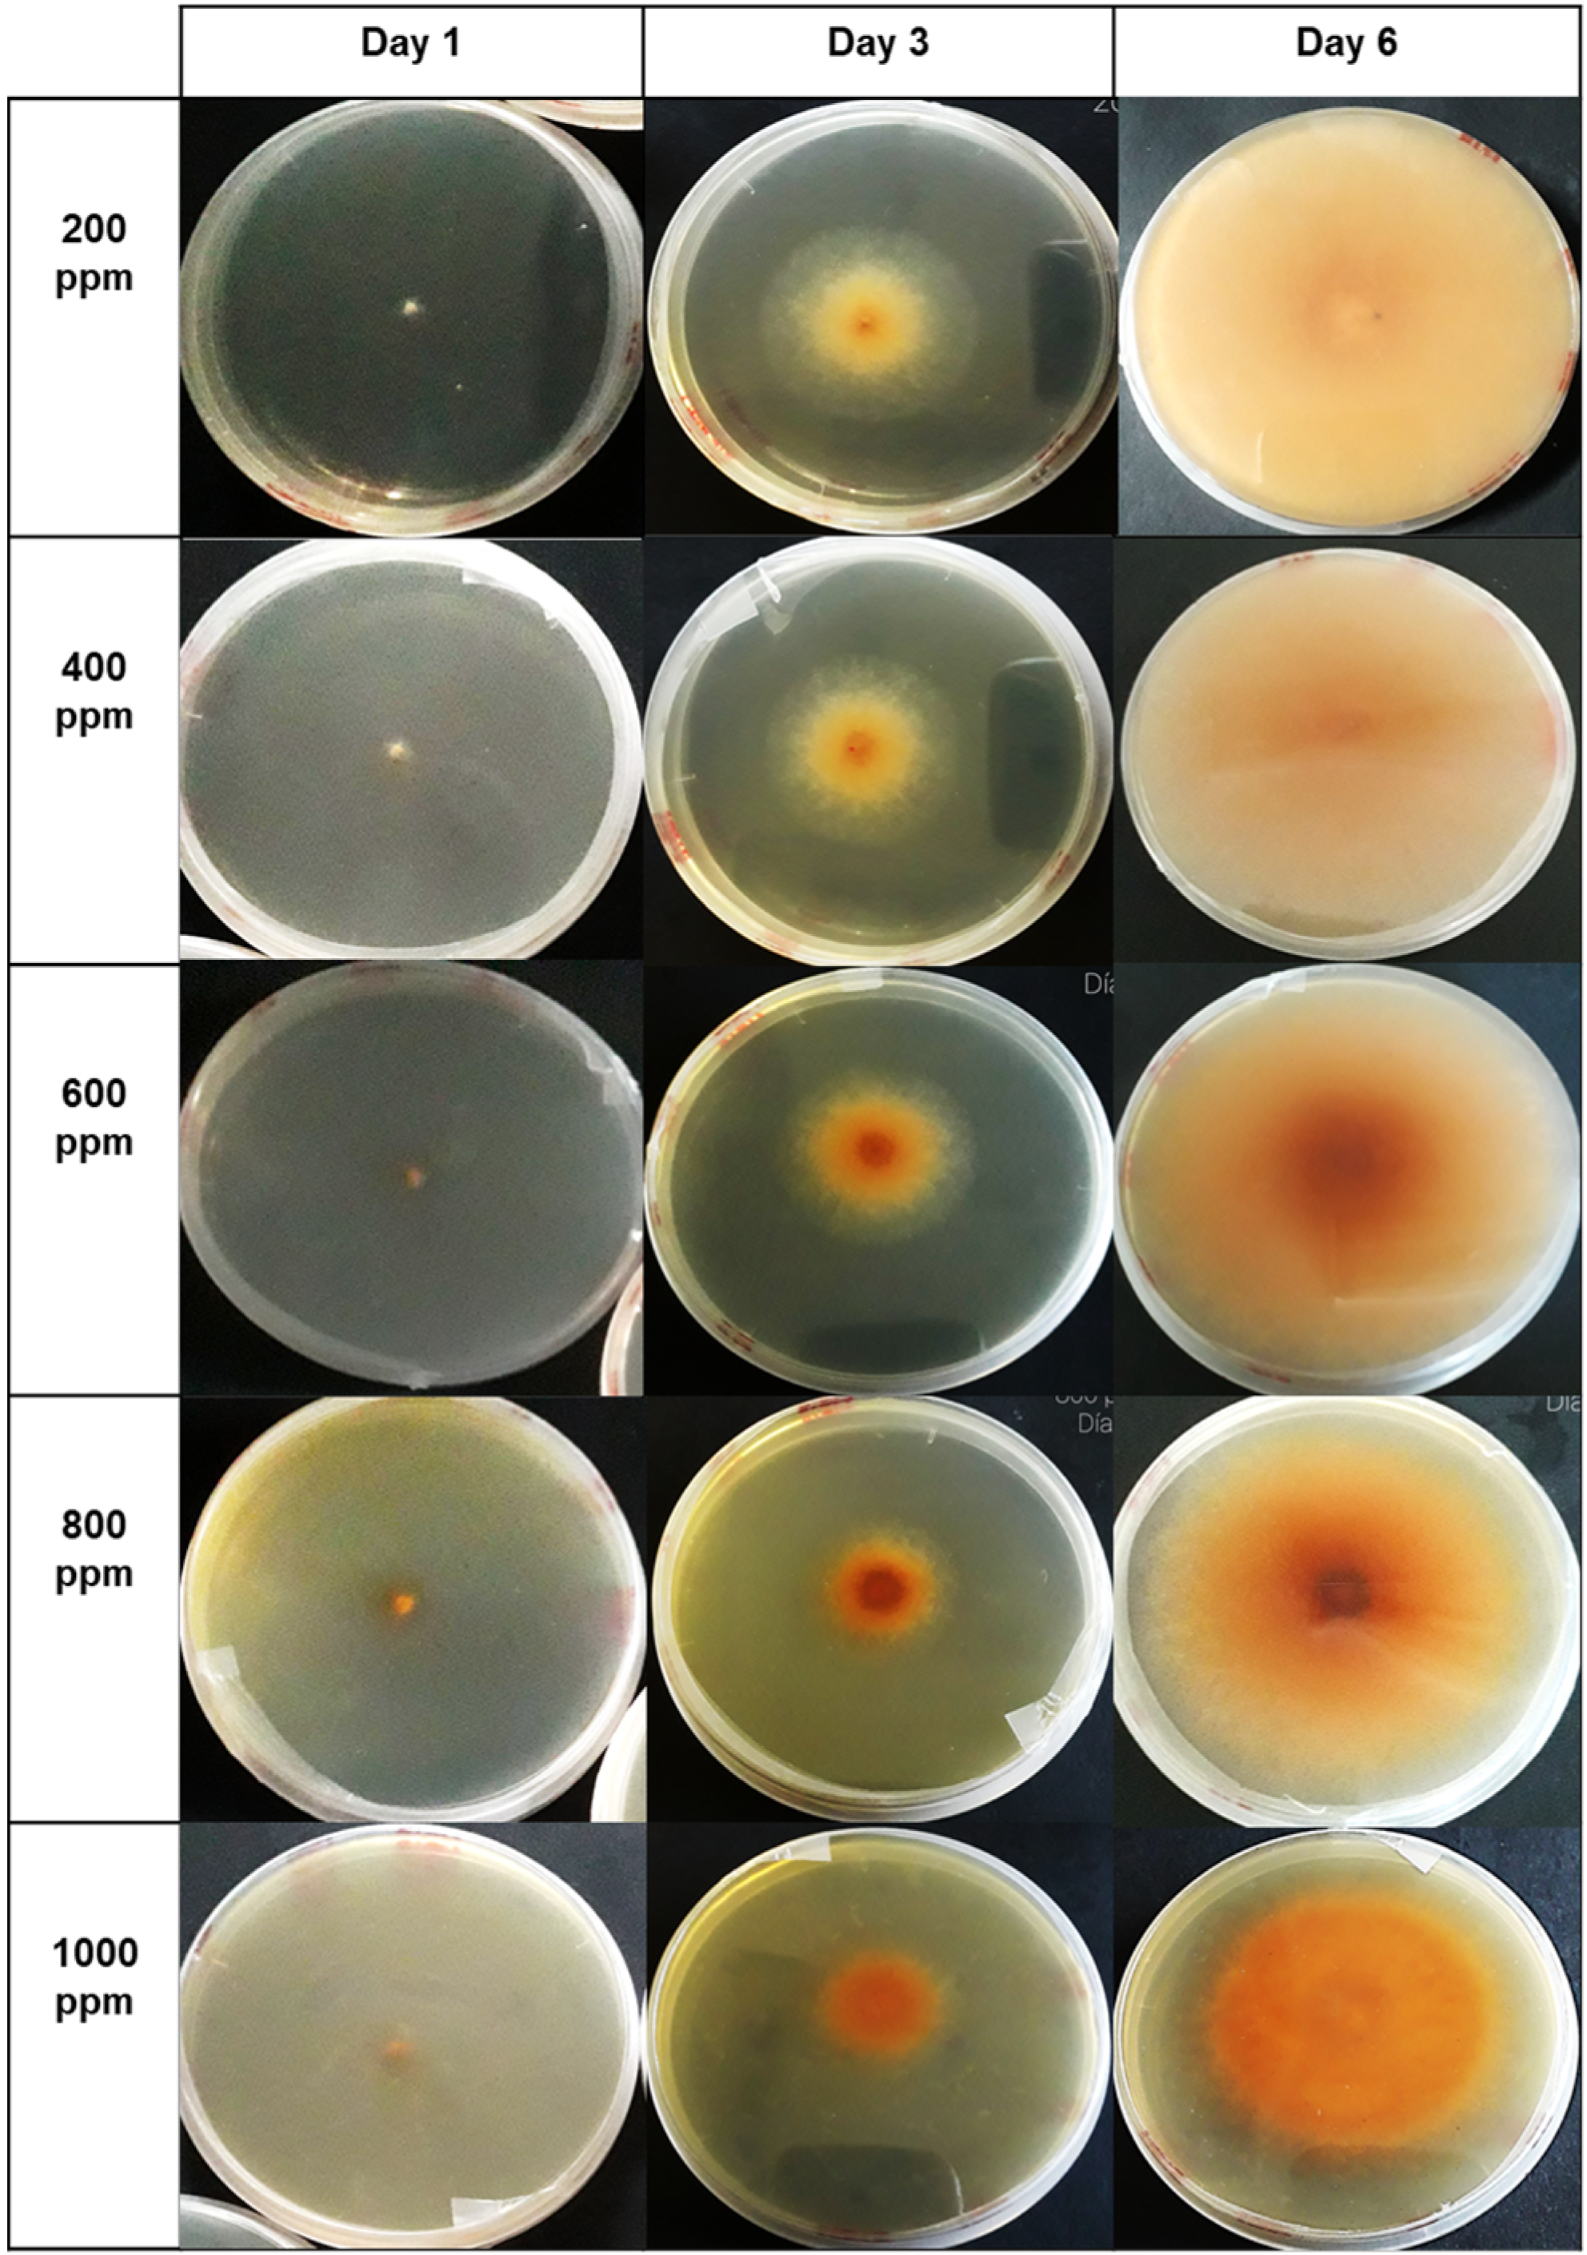
Microorganisms 12 01929 g009 Microorganisms 12 01929 g009

Hass Avocado (Persea americana Mill) Peel Extract Reveals Antimicrobial and Antioxidant Properties against Verticillium theobromae, Colletotrichum musae, and Aspergillus niger Pathogens Affecting Musa acuminata Colla Species, in Ecuador
Abstract
1. Introduction
2. Materials and Methods
2.1. Reagents
2.2. Obtention of Plant Material
2.3. Sample Preparation
2.4. Avocado Peel Extraction
2.5. Determination of the Total Soluble Polyphenol Content
2.6. HPLC Analysis of Avocado Peel Extract
2.7. Antioxidant Activity
DPPH Radical Scavenging Assay
2.8. ORAC Oxygen Radical Absorption Capacity Assay
2.9. Antifungal Activity Assay
2.9.1. Inoculum Preparation
2.9.2. Dilution Method in PDA Patato Dextrose Agar
2.10. Statistical Analysis
3. Results
3.1. Total Soluble Polyphenol Content
3.2. HPLC Analysis
3.3. Antioxidant Activity
3.4. Evaluation of the Antifungal Activity
4. Discussion
5. Conclusions
Author Contributions
Funding
Data Availability Statement
Acknowledgments
Conflicts of Interest
References
- Kupnik, K.; Primožič, M.; Kokol, V.; Knez, Ž.; Leitgeb, M. Enzymatic, Antioxidant, and Antimicrobial Activities of Bioactive Compounds from Avocado (Persea americana L.) Seeds. Plants 2023, 12, 1201. [Google Scholar] [CrossRef] [PubMed]
- Bhuyan, D.J.; Alsherbiny, M.A.; Perera, S.; Low, M.; Basu, A.; Devi, O.A.; Barooah, M.S.; Li, C.G.; Papoutsis, K. The Odyssey of Bioactive Compounds in Avocado (Persea americana) and Their Health Benefits. Antioxidants 2019, 8, 426. [Google Scholar] [CrossRef] [PubMed]
- Aguilar, R.; Briggit, R.; Dulanto, J.A. Fungi Associated with Fruit Crown Rot in Organic Banana in Piura, Peru. 2012. Available online: https://repository.unad.edu.co/handle/10596/29435 (accessed on 3 February 2024).
- Herrera, D. Evaluación de dos Alternativas Agroculturales y dos Productos Quimicos, para Reducir las Pérdidad Provocadas por los Hongos (Verticillium theobromae). 2005. Available online: http://biblioteca.usac.edu.gt/tesis/01/01_2186.pdf (accessed on 13 February 2024).
- Figueroa, J.G.; Borrás-Linares, I.; Del Pino-García, R.; Curiel, J.A.; Lozano-Sánchez, J.; Segura-Carretero, A. Functional ingredient from avocado peel: Microwave-assisted extraction, characterization and potential applications for the food industry. Food Chem. 2021, 352, 129300. [Google Scholar] [CrossRef] [PubMed]
- Cardoso, P.; Scarpassa, J.; Pretto-Giordano, L.; Otaguiri, E.; Yamada-Ogatta, S.; Nakazato, G.; Perugini, M.; Moreira, I.; Vilas-BÔas, G. Antibacterial activity of avocado extracts (Persea americana Mill.) against Streptococcus agalactiae. Phyton Int. J. Exp. Bot. 2017, 85, 218–224. [Google Scholar]
- FAO. Banana Facts and Figures; Food and Agriculture Organization of the United Nations: Rome, Italy, 2016. [Google Scholar]
- G. Cedeño y INIAP. Banano, Platano y Otras Musáceas. 2017. Available online: https://www.iniap.gob.ec/banano-platano-y-otras-musaceas/ (accessed on 3 February 2024).
- FAO. Banano-Análisis del Mercado 2020. Roma. 2022. Available online: https://openknowledge.fao.org/server/api/core/bitstreams/b7c671ae-c669-4f54-a7d2-c2fc9e4a489f/content (accessed on 3 February 2024).
- Alam, M.W.; Malik, A.; Rehman, A.; Hameed, A.; Sarwar, M.; Hussain, M.; Hussain, D.; Shafeeq, T. First Record of Colletotrichum gloeosporioides Causing Anthracnose of Banana in Pakistan. Plant Dis. 2021, 105, 2013. [Google Scholar] [CrossRef] [PubMed]
- Nguyen, T.V.; Nguyen, Q.D.; Nguyen, N.N.; Nguyen, T.T. Comparison of Phytochemical Contents, Antioxidant and Antibacterial Activities of Various Solvent Extracts Obtained from ‘Maluma’ Avocado Pulp Powder. Molecules 2021, 26, 7693. [Google Scholar] [CrossRef]
- Vargas, M.F.; Borries, E.; Aguilar, M. Development of gelatin/carboxymethylcellulose active films containing Hass avocado peel extract and their application as a packaging for the preservation of berries. Int. J. Biol. Macromol. 2022, 206, 1012–1025. [Google Scholar] [CrossRef]
- García-Vargas, M.C.; Contreras, M.d.M.; Gómez-Cruz, I.; Romero-García, J.M.; Castro, E. Avocado-Derived Biomass: Chemical Composition and Antioxidant Potential. Proceedings 2021, 70, 10. [Google Scholar]
- Melgar, B.; Días, M.; Ciric, A. Bioactive characterization of Persea americana Mill. by-products: A rich source of inherent antioxidants. Ind. Crops Prod. 2018, 111, 212–218. [Google Scholar] [CrossRef]
- Lyu, X.; Tuncay, O.; Barrow, C. Phenolic Compounds Profiling and Their Antioxidant Capacity in the Peel, Pulp, and Seed of Australian Grown Avocado. Antioxidants 2023, 12, 185. [Google Scholar] [CrossRef]
- Shirsath, S.; Sonawane, S. Intensification of extraction of natural products using ultrasonic irradiations—A review of current status. Chem. Eng. Process. Process Intensif. 2012, 53, 10–23. [Google Scholar] [CrossRef]
- Rodríguez, T.; Álvarez, B.; Jiménez, I. Efecto del tiempo y temperatura en la extracción acuosa de los compuestos fenólicos totales presentes en la raíz del género Smilax. Investig. Desarro. Cienc. Tecnol. Aliment. 2022, 7, 93–98. [Google Scholar]
- Tremocoldi, A. Exploration of avocado by-products as natural sources of bioactive compounds. PLoS ONE 2018, 13, e0192577. [Google Scholar] [CrossRef] [PubMed]
- De Sarabia, R.; Gallego, E.; Montoya, J. Procedimiento de Separación o Extracción con Fluidos Supercriticos Asistidos por Ultrasonidos de alta Intensidad. WO 2004/012859 A1, 21 October 2004. [Google Scholar]
- Wang, W.; Bostic, T.; Gu, L. Antioxidant capacities, procyanidins and pigments in avocados of different strains and cultivars. Food Chem. 2010, 122, 1193–1198. [Google Scholar] [CrossRef]
- Hirasawa, M.; Shimura, K.; Shimizu, A. Quantification and functional analysis of dietary fiber and polyphenols in avocado (Persea americana). J. Jpn. Soc. Food Sci. Technol. 2008, 55, 95–101. [Google Scholar] [CrossRef][Green Version]
- Anh Phan, D.T.; Huu Bui, T.; Thi Doan, T.Q. Inhibition of Melanosis in Whiteleg Shrimp (Litopenaeus vannamei) during Refrigerated Storage Using Extracts of Different Avocado (Persea americana Mill.) By-Products. Prev. Nutr. Food Sci. 2021, 26, 209–218. [Google Scholar] [CrossRef]
- Segovia, F.J.; Corral-Pérez, J.J.; Almajano, M.P. Avocado seed: Modeling extraction of bioactive compounds. Ind. Crops Prod. 2016, 85, 213–220. [Google Scholar] [CrossRef]
- Salas, L.; Moncayo, M.d.R.; Borroel, V. Composición fitoquímica y actividad antioxidante en tres variedades de albahaca por efecto de distintos solventes. Rev. Meicana De Cienc. Agric. 2022, 13, 113–123. [Google Scholar] [CrossRef]
- Diem Do, Q.; Angkawijaya, A.; Tran-Nguyen, P.L. Effect of extraction solvent on total phenol content, total flavonoid content, and antioxidant activity of Limnophila aromatica. J. Food Drug Anal. 2014, 22, 296–302. [Google Scholar]
- Apak, R.; Özyürek, M.; Güçlü, K. Antioxidant Activity/Capacity Measurement. 1. Classification, Physicochemical Principles, Mechanisms, and Electron Transfer (ET)-Based Assays. J. Agric. Food Chem. 2016, 64, 997–1027. [Google Scholar] [CrossRef]
- Trujillo, I.; Casas, N.; Pastene, E. Fractionation and Hydrolyzation of Avocado Peel Extract: Improvement of Antibacterial Activity. Antibiotics 2021, 10, 23. [Google Scholar] [CrossRef] [PubMed]
- Salmerón, M. Fracción Indigestible, Bioaccesibilidad In Vitro y Actividad Antioxidante, de Compuestos Fenólicos de la Cáscara de Aguacate Cv.“Hass”. Doctoral Dissertation, Centro de Investigación en Alimentación y Desarrollo, Hermosillo, Mexico, 2014. Available online: https://ciad.repositorioinstitucional.mx/jspui/bitstream/1006/391/1/SALMERON-RUIZ-ML14.pdf (accessed on 23 March 2024).
- Estrada, A.; Villanueva, J.; Gonzalez, G.; Alcántar, V. Determination of the total antioxidant capacity of food and human plasma by photochemiluminescence: Correlation with spectrophotometric (FRAP) and fluorometric (ORAC) assays. Rev. Espec. Cienc. Químico-Biológicas 2020, 23, e20200244. [Google Scholar]
- Perumal, A.; Sellamuthu, P.; Nambiar, R. Antifungal activity of five different essential oils in vapor phase for the control of Colletotrichum gloeosporioides and Lasiodiplodia theobromae in vitro and on mango. Int. J. Food Sci. Technol. 2016, 51, 411–418. [Google Scholar] [CrossRef]
- Mapook, A.; Hyde, K.D.; Hassan, K. Ten decadal advances in fungal biology leading towards human well-being. Fungal Divers. 2022, 116, 547–614. [Google Scholar] [CrossRef] [PubMed]
- Aliaga, C. Eefecto de los Extractos Naturales en el Control de la Podredumbre de la Corona del Banano. 2005. Available online: https://repositorio.umsa.bo/xmlui/handle/123456789/14047 (accessed on 27 March 2024).
- Mesa, V.; Marín, P. Fungicidas a partir de extractos vegetales: Una alternativa en el manejo integrado de hongos fitopatógenos. Rev. De Investig. Agropecu. 2019, 45, 23–30. [Google Scholar]
- López, A.; Veléz, M. Evaluation of vegetable extracts for control of the pathogenic fungi in banana and strawberry in post harvest storage. Acta Agronómica 2006, 55, 39–44. [Google Scholar]
- Meng, X.; Fangcheng, J.; Zhu, L. Antifungal Activities of Crude Extractum from Camellia semiserrata Chi (Nanshancha) Seed Cake Against Colletotrichum musae, Colletotrichum gloeosporioides and Penicillium italicum in vitro and in vivo Fruit Test. Plant Pathol. J. 2015, 31, 414–420. [Google Scholar] [CrossRef][Green Version]
- Maqbool, M.; Ramachandran, S.; Smith, D. Control of postharvest anthracnose of banana using a new edible composite coating. Crop Prot. 2010, 29, 1136–1141. [Google Scholar] [CrossRef]
- Skenderidis, P.; Leontopoulos, S.; Petrotos, K. The In Vitro and In Vivo Synergistic Antimicrobial Activity Assessment of Vacuum Microwave Assisted Aqueous Extracts from Pomegranate and Avocado Fruit Peels and Avocado Seeds Based on a Mixtures Design Model. Plants 2021, 10, 1757. [Google Scholar] [CrossRef]
- Vera-Reyes, I.; Altamirano-Hernández, J.; Reyes-de la Cruz, H.; Granados-Echegoyen, C.A.; Loera-Alvarado, G.; López-López, A.; Garcia-Cerda, L.A.; Loera-Alvarado, E. Inhibition of Phytopathogenic and Beneficial Fungi Applying Silver Nanoparticles In Vitro. Molecules 2022, 27, 8147. [Google Scholar] [CrossRef]
- Rintala, H.; Pitkäranta, M.; Täubel, M. Microbial Communities Associated with House Dust. In Advances in Applied Microbiology; Academic Press: Cambridge, MA, USA, 2012; pp. 75–120. [Google Scholar]
- Rodríguez-Guzmán, C.A.; Montaño-Leyva, B.; Velázquez-Estrada, R.M.; Sánchez-Burgos, J.A.; de Lourdes García-Magaña, M.; González-Estrada, R.R.; Gutiérrez-Martínez, P. Estado actual de métodos alternativos, de control de hongos y su efecto en la calidad postcosecha de frutos de jitomate (Solanum lycopersicum). TIP Rev. Espec. Cienc. Químico-Biológicas 2021, 24, 1–15. [Google Scholar] [CrossRef]
- Paschos, T.; Xiros, C.; Christakopoulos, P. Ethanol effect on metabolic activity of the ethalogenic fungus Fusarium oxysporum. BMC Biotechnol. 2015, 15, 15. [Google Scholar] [CrossRef] [PubMed]
- Soto, M.; Rosales, M. Effect of solvent and solvent-to-solid ratio on the phenolic extraction and the antioxidant capacity of extracts from Pinus durangensis and Quercus sideroxyla bark. Maderas Cienc. Tecnol. 2016, 18, 701–714. [Google Scholar] [CrossRef]
- Hernandéz, S.; Quiroz, C.; Ramírez, M.; de Jesús, E.R.; Aguílar, M. Optimización del proceso de extracción asistida por ultrasonido de compuestos fenólicos de Justicia spicigera Schltdl. mediante la metodología de superficie de respuesta. Rev. Espec. En Cienc. Químico-Biológicas 2021, 23, 1–7. [Google Scholar] [CrossRef]
- Donoso, C.D. Extracción de Polifenoles de la Cascara y Semilla de Aguacate Hass; Escuela Politecnica Nacional: Quito, Ecuador, 2023. [Google Scholar]
- Gárcia, G.B.; Davidov Pardo, G.; Arroqui, C.; Virseda, P.; Arroyo, M.M. Intra-laboratory validation of microplate methods for total phenolic content and antioxidant activity on polyphenolic extracts, and comparison with conventional spectrophotometric methods. J. Sci. Food Agric. 2014, 95, 204–209. [Google Scholar] [CrossRef]
- Dávalos, A.; Gómez, C.; Begoña, B. Extending the applicability of the oxygen radical absorbance capacity (ORAC-fluorescein) assay. J. Agric. Food Chem. 2004, 52, 48–54. [Google Scholar] [CrossRef]
- Ruiz Quiroz, J.R. Actividad Antifungica In Vitro y Concentración Mínima Inhibitoria Mediante Microdilución de ocho Plantas Medicinales. Post-grado tesis, Universidad Nacional Mayor de San Marcos, Facultad de Farmacia y Bioquímica Nidad Lima, Lima, Perú, 2013. [Google Scholar]
- Pérez Revelo, K.E. Evaluación del uso de Aceites Esenciales como Método Alternativo para el Control de Podredumbres en piña (Ananas comosus var. MD-2) Durante el Periodo Poscosecha. Ph.D. Thesis, Facultad de Ingenieria Quimica y Agroindustria Quito, Quito, Ecuador, 2016; 122p. [Google Scholar]

| TPC (mg GAE/g DW) | |
|---|---|
| TI | 138.47 ± 0.006 a |
| TII | 129.55 ± 0.010 b |
| TIII | 130.94 ± 0.003 b |
| TIV | 124.89 ± 0.013 c |
| Average Concentration (mg/L) | Retention Time (min) | |
|---|---|---|
| chlorogenic acid | 74.91 | 14.640 |
| catechin | 266.09 | 14.851 |
| epicatechin | 544.252 | 15.520 |
| DPPH (µmol Trolox/g DW)/% Inhibition | ORAC (µmol Trolox/g DW) | |
|---|---|---|
| TI | 833.32 ± 0.0051 b/84.97% | 1889.1 ± 0.50 a |
| TII | 822.80 ± 0.0059 a/83.87% | 1869.8 ± 0.60 ab |
| TIII | 823.41 ± 0.0088 a/83.94% | 1881.5 ± 0.21 b |
| TIV | 824.33 ± 0.0079 a/84.04% | 1843.7 ± 0 b |
| Concentrations ) | Verticillium theobromae (Day 16) | Colletotrichum musae (Day 6) |
|---|---|---|
| 1000 | 61.59 a (0.704) | 35.67 a (0.610) |
| 800 | 50.92 b (0.610) | 33.54 b (0.704) |
| 600 | 28.97 c (0.610) | 22.56 c (0.704) |
| 400 | 19.82 d (0.610) | 9.45 d (0.610) |
| 200 | 8.23 e (0.610) | 5.49 e (1.220) |
| Control PDA | 0.30 f (0.000) | 0 f (0.000) |
| Concentrations () | Aspergillus niger (Day 16) |
|---|---|
| 2200 | 27.59 a (0.584) |
| 1900 | 16.62 b (0.584) |
| 1600 | 11.43 c (0.584) |
| 1300 | 5.95 d (0.584) |
| 1000 | 3.05 e (0.584) |
| Control PDA | 0 f (0.000) |
Disclaimer/Publisher’s Note: The statements, opinions and data contained in all publications are solely those of the individual author(s) and contributor(s) and not of MDPI and/or the editor(s). MDPI and/or the editor(s) disclaim responsibility for any injury to people or property resulting from any ideas, methods, instructions or products referred to in the content. |
© 2024 by the authors. Licensee MDPI, Basel, Switzerland. This article is an open access article distributed under the terms and conditions of the Creative Commons Attribution (CC BY) license (https://creativecommons.org/licenses/by/4.0/).
Share and Cite
Donoso, C.; Raluca, M.A.; Chávez-Jinez, S.; Vera, E. Hass Avocado (Persea americana Mill) Peel Extract Reveals Antimicrobial and Antioxidant Properties against Verticillium theobromae, Colletotrichum musae, and Aspergillus niger Pathogens Affecting Musa acuminata Colla Species, in Ecuador. Microorganisms 2024, 12, 1929. https://doi.org/10.3390/microorganisms12091929
Donoso C, Raluca MA, Chávez-Jinez S, Vera E. Hass Avocado (Persea americana Mill) Peel Extract Reveals Antimicrobial and Antioxidant Properties against Verticillium theobromae, Colletotrichum musae, and Aspergillus niger Pathogens Affecting Musa acuminata Colla Species, in Ecuador. Microorganisms. 2024; 12(9):1929. https://doi.org/10.3390/microorganisms12091929
Chicago/Turabian StyleDonoso, Caterine, Mihai A. Raluca, Stephanie Chávez-Jinez, and Edwin Vera. 2024. "Hass Avocado (Persea americana Mill) Peel Extract Reveals Antimicrobial and Antioxidant Properties against Verticillium theobromae, Colletotrichum musae, and Aspergillus niger Pathogens Affecting Musa acuminata Colla Species, in Ecuador" Microorganisms 12, no. 9: 1929. https://doi.org/10.3390/microorganisms12091929
APA StyleDonoso, C., Raluca, M. A., Chávez-Jinez, S., & Vera, E. (2024). Hass Avocado (Persea americana Mill) Peel Extract Reveals Antimicrobial and Antioxidant Properties against Verticillium theobromae, Colletotrichum musae, and Aspergillus niger Pathogens Affecting Musa acuminata Colla Species, in Ecuador. Microorganisms, 12(9), 1929. https://doi.org/10.3390/microorganisms12091929

